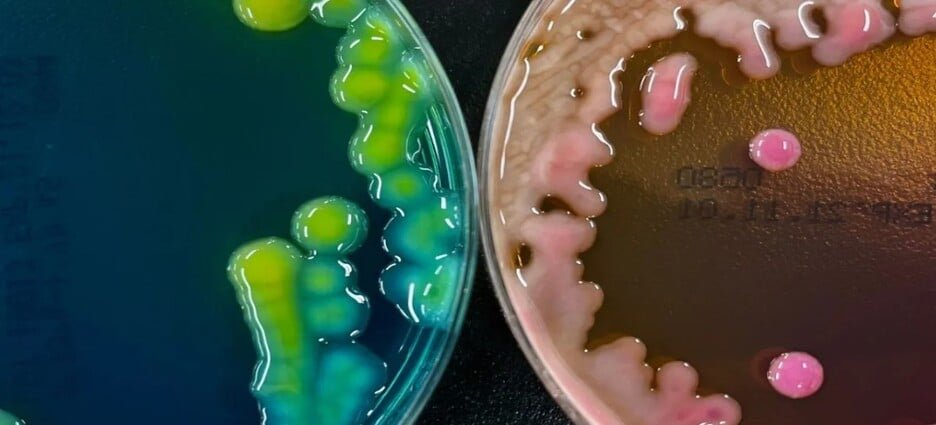

ESTADO DE MÉXICO
Congreso de Edomex aprueba en comisiones reforma judicial
Las comisiones unidas de Gobernación y Punto Constitucionales, con la de Procuración y Administración de Justicia, aprobaron el dictamen de reforma, adiciones y derogaciones a la Constitución mexiquense para hacer los ajustes al Poder Judicial del Estado de México que…
Galardonan a fotógrafos indígenas del Edomex por retratar pueblos originarios
Fotógrafas y fotógrafos de comunidades indígenas de la entidad mexiquense fueron premiados por haber plasmado en imagen la naturaleza de los pueblos originarios y la cotidianidad de sus habitantes, en un concurso llevado a cabo por la Secretaría General de…
Emiten alerta epidemiológica por brote de bacteria Klebsiella oxytoca en Edomex
La Secretaría de Salud Federal emitió una alerta epidemiológica debido a un brote de Infección del Torrente Sanguíneo (ITS) causado por Klebsiella oxytoca, una bacteria relacionada con la posible contaminación de Nutrición Parenteral (NPT) o insumos utilizados en su aplicación. Klebsiella…
Inicia proceso de renovación del Poder Judicial Federal en Edomex
En sesión extraordinaria se instaló el Consejo Local del Instituto Nacional Electoral del Estado de México para la elección del Poder Judicial Federal en la entidad, y las y los consejeros expresaron que aún hay diversas dudas sobre este proceso,…